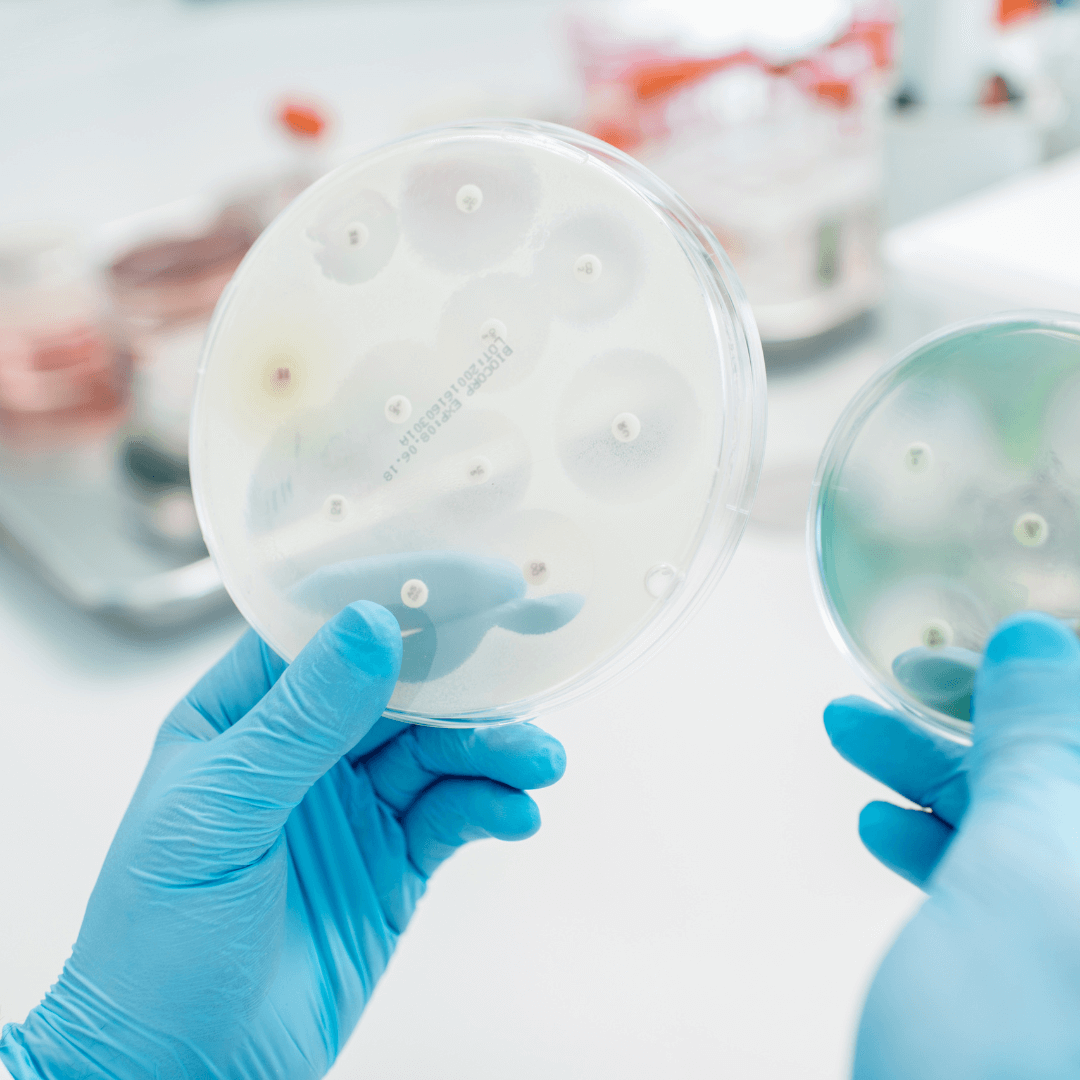

Intervieni tempestivamente con SALVALAT lavanda funzionale intramammaria
Riduce o annulla il processo di cronicizzazione della mastite garantendo la possibilità di mantenere l’animale in allevamento.
Contribuisce a gestire in modo conveniente la media geometrica delle cellule somatiche.

SALVALAT Lavanda Funzionale per vacche da latte della Linea Salus Thermae: si tratta di una lavanda termale intramammaria di origine bioinorganica, ha lo scopo di “ripulire e rimuovere” il biofilm batterico cresciuto nei dotti galattofori e nella cisterna della mammella nelle vacche da latte. Detta lavanda esplica la sua funzione in superficie con una attività locale e non sistemica. Non è un antibiotico. Non penetra e non migra nel corpo dell’animale.
LE CELLULE SOMATICHE NEL LATTE – UN PROBLEMA CONOSCIUTO E ATTUALE

CELLULE SOMATICHE COSA SONO? QUANTE SONO?
In un quarto sano sono meno di 200 mila.
Tendenzialmente meno di 100 mila:
- 0-7 % Cellule epiteliali
- 60 % Macrofagi
- 30 % Linfociti B e T
- 10 % Neutrofili PMN
SONO LA RISPOSTA DI TIPO IMMUNITARIO ALL’INGRESSO IN MAMMELLA DI UN PATOGENO (BATTERI – FUNGHI – ALGHE) CHE DETERMINA INFIAMMAZIONE.
MECCANISMO DI PRODUZIONE

COSA DETERMINA IL LORO INCREMENTO
QUANTO COSTA LA MASTITE ALL’ALLEVAMENTO?

PERDITA PRODUTTIVA
200.000 = 0 %
500.000 = 6 %
1.000.000 = 18 %
1.500.000 = 29 %
ALTRE PERDITE (DEPREZZAMENTO LATTE, COSTI TERAPIE, LATTE ELIMINATO, AUMENTO RIMONTA)
LA DIRETTIVA COMUNITARIA
⠀
⠀
(REG. 852/2004)
NUOVO REGIME RELATIVO ALL’IGIENE DEI PRODOTTI ALIMENTARI
⠀
⠀
REG.178/2002
⠀
⠀
(REG. 854/2004)
CONTROLLI UFFICIALI SUI PRODOTTI DI ORIGINE ANIMALE DESTINATI AL CONSUMO DA PARTE DELL’UOMO
⠀
⠀
(REG. 853/2004)
REGOLE SPECIFICHE D’IGIENE APPLICABILI AI PRODOTTI ALIMENTARI DI ORIGINE ANIMALE
⠀
⠀
(REG. 882/2004)
CONTROLLI UFFICIALI DEI MANGIMI E DEGLI ALIMENTI
⠀
⠀
(DIRETTIVA 2002/99 CE)
REGOLE DI POLIZIA SANITARIA CHE REGOLAMENTANO LA PRODUZIONE E LA DISTRIBUZIONE ANIMALE DESTINATI AL CONSUMO UMANO
⠀
I PARAMETRI (MEDIA GEOMETRICA MOBILE)

IL SISTEMA DI SORVEGLIANZA
DIAGRAMMA PER L’ESECUZIONE DI CONTROLLI ANALITICI UFFICIALI

DESTINO DELLA MASTITE SUB CLINICA
( CELLULE SOMATICHE ELEVATE )
GUARIGIONE SPONTANEA O TERAPIA ANTIBIOTICA

PUBBLICATO IL PIANO NAZIONALE CONTRO L’ANTIBIOTICO-RESISTENZA
Per ogni nuovo antimicrobico naturale esiste un meccanismo di resistenza in natura. L’introduzione degli antibiotici in medicina, umana e veterinaria, ha generato un’ulteriore pressione selettiva.
Approvato dalla conferenza STATO-REGIONI, IL PNCAR 2017-2020, il primo piano nazionale contro l’antibiotico – resistenza, è pubblicato sul sito del ministero della salute.
CATEGORIZZAZIONE DEGLI ANTIBIOTICI INSERIMENTO DEI CIA
⠀
EMA
⠀
⠀
CATEGORIZZAZIONE DEGLI ANTIBIOTICI DESTINATI ALL’IMPIEGO NEGLI ANIMALI PER UN USO PRUDENTE E RESPONSABILE
⠀
L’uso prudente e responsabile di antibiotici sia negli animali che negli esseri umani può ridurre il rischio di sviluppo della resistenza da parte dei batteri.
Questo aspetto è particolarmente importante per gli antibiotici utilizzati per uso sia umano che veterinario e per quelli che rappresentano l’ultima linea di trattamento in caso di infezioni gravi nelle persone.
⠀
⠀
⠀
One Health
(una sola salute)
La resistenza agli antibiotici si può diffondere tra gli animali,
gli esseri umani e l’ambiente.
⠀
⠀
⠀
Il gruppo di esperti ad hoc di consulenza antimicrobica (AMEG) ha classificato gli antibiotici in base all’effetto che il possibile sviluppo della resistenza antimicrobica dovuto al loro utilizzo negli animali può avere sulla salute pubblica e in base alla necessità di utilizzarli nella medicina veterinaria.
LA TRACCIABILITA’ DEL FARMACO VETERINARIO

ATTIVAZIONE DEL REGISTRO ELETTRONICO

L’USO DELL’ ANTIBIOTICO SUL BOVINO
LA NORMATIVA OLTRE AD INSERIRE UNA CATEGORIZZAZIONE DEGLI ANTIBIOTICI DA USARE SUL BOVINO PROIBISCE QUALSIASI FORMA DI PROFILASSI ANTIBIOTICA. UNA DELLE PROFILASSI ANTIBIOTICHE PIU’ DIFFUSE E‘ RAPPRESENTATA DALLA MESSA IN ASCIUTTA.
TERAPIA IN ASCIUTTA
TERAPIA ANTIBIOTICA SELETTIVA IN ASCIUTTA (SDCT)
La terapia antibiotica in asciutta selettiva ha 1 solo obiettivo:
1. Curare infezioni esistenti al momento dell’asciutta.
La percentuale delle bovine da sottoporre a terapia è legata allo stato sanitario della mandria e quindi indirettamente alla media delle cellule somatiche della massa.

PROGRAMMI INTERNAZIONALI DI CONTROLLO DELLA MASTITE
1. Definire degli obiettivi per la sanità della mammella
2. Garantire un ambiente pulito, asciutto e confortevole
3. Garantire una corretta routine di mungitura
4. Garantire una adeguata manutenzione ed utilizzo della macchina mungitrice
5. Mantenere una registrazione dei dati puntuale
6. Gestire correttamente le mastiti cliniche durante la lattazione
7. Gestione efficace delle vacche asciutte e delle manze gravide
8. Garantire la biosicurezza per i patogeni contagiosi e la riforma delle vacche croniche
9. Monitoraggio regolare dello stato mammario
10. Revisione periodica del piano di controllo delle mastiti
IL DESTINO DEI CRONICI IL PROBLEMA DELLE “VACCHE CRONICE”
– In ogni azienda esiste una percentuale di animali che presentono costantemente conte cellulari elevate.
– Sono spesso animali con uno o più capezzoli in meno.
– Hanno in anamnesi diversi episodi di mastite clinica.
– Generalmente soggetti di età avanzata (più di quattro lattazioni).
– Portatori di infezioni croniche della mammella da germi di varia natura.
– Hanno mammelle che presentano vari gradi di danno anatomico.
CELLULE SOMATICHE UN PROBLEMA TUTT’ALTRO CHE RISOLTO
- PROTOCOLLI DI LAVORO RESTRITTIVI
- RIDUZIONE DELL’IMPIEGO DEGLI ANTIBIOTICI
- ANTIBIOTICI CON TEMPI DI SOSPENSIONE LUNGHI
- RINUNCIA ALLE TERAPIE
- FORMAZIONE DEI CRONICI
- PERDITA ECONOMICA COSTANTE
UNA NUOVA PROPOSTA DI MERCATO DA INSERIRE IN ALLEVAMENTO
SALVALAT Lavanda Funzionale

SALVALAT LAVANTA FUNZIONALE
RIDUCE O ANNULLA IL PROCESSO DI CRONICIZZAZIONE DELLA MASTITE GARANTENDO LA POSSIBILITA’ DI MANTENERE L’ ANIMALE IN ALLEVAMENTO.
⠀
CONTRIBUISCE A GESTIRE IN MODO CONVENIENTE LA MEDIA GEOMETRICA DELLE CELLULE SOMATICHE.
CARATTERISTICHE DI IMPIEGO

Salvalat Lavanda Funzionale
Con Estratto Glicolico Cetriolo Ph 5.6

DESCRIZIONE:
SALVALAT LAVANDA FUNZIONALE della linea Animal Health Line:
si tratta di una lavanda funzionale intramammaria di origine bioinorganica, ha lo scopo di “ripulire e rimuovere” il biofilm batterico cresciuto nei dotti galattofori e nella cisterna della mammella nelle vacche da latte. Detta lavanda esplica la sua funzione in superficie con una attività locale e non sistemica. Non è un antibiotico. Non penetra e non migra nel corpo dell’animale.
CATETERE MONOUSO: Il catetere è formato da un tubo con 3 fori nella parte finale che andrà introdotto nel capezzolo della mammella e da un connettore da innestare sull’erogatore della bomboletta.
INDICAZIONI D’USO: La lavanda è utilizzata per favorire l’eliminazione del biofilm batterico all’interno della mammella delle vacche da latte.
MODALITÀ D’USO: Somministrare a mammella svuotata subito dopo la mungitura previa accurata pulizia e disinfezione del capezzolo. Una irrigazione per singolo capezzolo. Inserire il catetere nel capezzolo per almeno 10/12cm. Evitare il contatto con la parte del catetere che verrà inserita nel capezzolo, in quanto sterile. I residui della lavanda, compreso il biofilm batterico, sono eliminati con le mungiture successive al trattamento. Non utilizzare il latte munto nelle prime 24 ore successive al trattamento.
Utilizzare l’intero contenuto della bombola per ogni singola applicazione.
COMPOSIZIONE: Propylene Glycol, Aqua (Deionized Water), Glycerin, Cucumis Sativus Fruit Extract, Polysorbate 20, PVP.
PROPELLENTE: Azoto.
CONTROINDICAZIONI: Ipersensibilità nota verso i componenti.
POSSIBILI EFFETTI COLLATERALI: Sono possibili reazioni dell’animale durante il trattamento. La reazione non è sintomo di dolore, ma del disagio dell’animale.
AVVERTENZE: Agitare la bomboletta prima dell’uso. La bomboletta va tenuta perfettamente verticale!
L’uso improprio può determinare l’inefficacia del prodotto.
Tenere lontano dalla portata dei bambini.
CONDIZIONI DI CONSERVAZIONE: Mantenere il prodotto sotto i 40°C
CONTENUTO: 100 ml / 150 ml
SCADENZA: 24 mesi dalla data del lotto di produzione.
PRODUTTORE: CNT Salus Mundi S.r.l.; Via Cardano 32, 43036 – Fidenza (PR) – ITALY; www.salusthermae.com; [email protected]; tel.:+39 0524 681024.
Everton S.r.l.; Via Azzano 11, 37064 – Povegliano V.se (VR) – ITALY.
DISTRIBUTORE ESCLUSIVO: D.e.r.p.a. Mn-cr S.r.l.; Via L.Benati 54, 46048 – Roverbella (MN) – ITALY; [email protected].

Agitare la bomboletta prima dell’uso. Rimuovere il tappo del flacone spray SALVALAT Lavanda Funzionale e inserire il catetere nell’erogatore del flacone.

Assicurarsi che il catetere sia fissato in modo sicuro.

Inserire il catetere nel capezzolo per almeno 10 / 12 cm. Evitare il contatto con la parte del catetere che verrà inserita nel capezzolo, in quanto sterile. Premere e utilizzare l’intero contenuto della bombola.

La bomboletta va tenuta perfettamente verticale! L’uso improprio può determinare l’inefficacia del prodotto.
A CHI PUO’ SERVIRE IL PRODOTTO
A TUTTE LE AZIENDE CHE PRODUCONO LATTE
NON SOLO BOVINI, MA ANCHE OVI-CAPRINI

DOVETE SAPERE CHE:

COME UTILIZZARE IL PRODOTTO
Sulle nuove infezioni per evitare che diventino croniche e quindi difficilmente curabili.
In questa situazione i microbi sono ancora aggredibili, non si sono ancora incistati, non hanno ancora creato il Biofilm.
Si possono avere buoni risultati anche sui microbi come Staf. Aureus e Strep. Uberis.
ANIMALI SCELTI PER LA TERAPIA IN FEBBRAIO 2022

ESITI DELLA TERAPIA IN APRILE 2022


CONCLUDENDO:
In conclusione, l’utilizzo sistematico del prodotto Salvalat Lavanda Funzionale, insieme a un adeguato controllo sulla tecnica di mungitura e sulla macchina da mungere, si dimostra fondamentale per ottenere una salute della mandria a livello di mammella soddisfacente.
L’efficacia a lungo termine di questo prodotto si manifesta attraverso benefici tangibili, come la riduzione della riforma per mastiti croniche e il mantenimento di una conta cellulare al di sotto del limite critico di 200.000.
Tali vantaggi si traducono in una significativa diminuzione delle perdite economiche, considerando che una bovina con alti livelli di cellule durante la lattazione può produrre fino a 500-700 litri di latte in meno e richiedere la sostituzione con una nuova manza, con un costo medio di 2500 €.
Pertanto, l’adozione di Salvalat Lavanda Funzionale e le adeguate pratiche di gestione rappresentano un investimento prezioso per garantire la salute delle mammelle delle bovine e ottimizzare i rendimenti economici dell’attività zootecnica.
SCHEMA MUNGITURA

STEP 1: STRIP

COME PRIMO INTERVENTO FARE ALMENO 5-6 GETTI PER CAPEZZOLO.
IN QUESTO MODO SI VEDONO GLI ANIMALI CHE HANNO STOPPINI, LATTE NON BUONO ECC. …
STEP 2: DIP

DISINFETTARE
STEP 3: DRY

ASCIUGARE
STEP 4: APPLY

ATTACARE
STEP 5: DIP

DISINFETTARE
Innovazione e Sviluppo nel settore zootecnico
Benvenuti alla nostra azienda, un punto di riferimento per l’innovazione e lo sviluppo nel campo della zootecnia. Siamo orgogliosi di presentarvi il nostro reparto di Ricerca & Sviluppo, che lavora costantemente per migliorare e sviluppare i nostri prodotti, offrendo soluzioni avanzate per gli allevatori.
Nel nostro reparto, dedicato a test rigorosi e approfonditi, combiniamo studi teorici e pratici per garantire l’eccellenza dei nostri prodotti. Collaboriamo anche con laboratori esterni per ottenere le certificazioni necessarie, assicurando la massima qualità e sicurezza.
Siamo entusiasti di annunciare che siamo nella fase finale dello sviluppo di nuovi prodotti che arricchiranno la nostra gamma e forniranno soluzioni specifiche per le esigenze degli allevatori:
Il primo prodotto che stiamo per lanciare è il Salvalat Lavanda Funzionale Biologico. Si tratta di una soluzione completamente naturale con certificazione biologica, che garantirà agli allevatori un prodotto funzionale e al passo con un mercato dedicato. Non solo offriremo un prodotto di alta qualità, ma anche la possibilità di ottenere maggiori guadagni grazie a un prezzo di vendita leggermente aumentato.
Inoltre, stiamo lavorando su un prodotto innovativo per le operazioni di pre e post mungitura, il Dipping per Mungitura Ovini, Caprini e Bovini. Questa soluzione prevede l’immersione del capezzolo nella nostra soluzione, che aiuterà a prevenire patologie legate a pratiche di mungitura errate o disinfezioni non corrette. Questo prodotto all’avanguardia nel campo della zootecnia si adatta alle diverse esigenze di ovini, bovini e caprini.
Un altro ambito su cui stiamo concentrando la nostra ricerca è la messa in asciutta delle vacche da latte. Sappiamo quanto sia importante della mesa in asciutto della vacca da latte per prevenire la mastite, e stiamo sviluppando una variante del Salvalat appositamente studiata per eliminare gli agenti eziologici responsabili di questa patologia. Inoltre, stiamo lavorando su un protocollo operativo che riguarderà tutte le operazioni di messa in asciutta delle vacche da latte, al fine di garantire risultati ottimali. Questo progetto sarà un importante passo avanti nel settore.
Siamo entusiasti di condividere queste novità con voi e siamo certi che i nostri nuovi prodotti rappresenteranno un valore aggiunto per gli allevatori, offrendo soluzioni efficaci e innovative per migliorare la gestione e la salute del bestiame.
Grazie per l’attenzione e siamo a disposizione per ulteriori informazioni e approfondimenti sui nostri prodotti e sul nostro impegno verso l’innovazione nella zootecnia.








Sarei interessata al lavaggio mammario x bovine